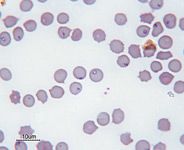

Cats are host to a variety of internal and external parasites. Despite the documented prevalence and zoonotic importance of these parasites, many pet owners and some veterinarians aren't convinced that comprehensive feline parasite control strategies are needed. This viewpoint may stem from the previous lack of safe, effective, and convenient broad-spectrum parasiticides and the difficulties in acquiring adequate fecal samples. Fortunately, newer broad-spectrum agents (Table 1), particularly those with label claims against heartworms and fleas, allow veterinarians to eliminate a higher percentage of feline parasites. Let's review some of the key feline parasites and discuss new strategies for controlling them.